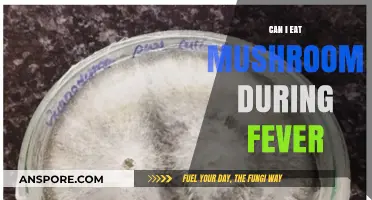
Can You Eat Mushrooms During Fever? Nutrition and Recovery Tips

When considering whether you can eat mushroom stalks, it's important to know that many common edible mushrooms, such as button, cremini, and portobello mushrooms, have stalks that are perfectly safe to consume. However, the texture of the stalks can be tougher or woodier compared to the caps, so some people prefer to remove or trim them. For wild mushrooms, caution is crucial, as some species have stalks that are either inedible or toxic. Always ensure proper identification and preparation before consuming any part of a wild mushroom. If in doubt, consult a reliable guide or expert to avoid potential risks.
| Characteristics | Values |
|---|---|
| Edibility | Generally safe to eat for most common mushrooms (e.g., button, cremini, portobello) |
| Texture | Can be woody or tough, especially in mature mushrooms; often removed for texture preference |
| Flavor | Mild, similar to the mushroom cap; may be slightly earthy or bland |
| Nutritional Value | Contains fiber, vitamins, and minerals, though in smaller amounts compared to the cap |
| Preparation | Can be cooked (sautéed, roasted, etc.) or used in stocks; trimming tough ends is recommended |
| Exceptions | Some wild mushrooms have toxic stalks; always verify species before consumption |
| Common Practice | Often discarded due to texture, but perfectly edible in most cultivated varieties |
| Culinary Use | Used in soups, stews, or blended dishes where texture is less important |
Explore related products
What You'll Learn
- Edible vs. Poisonous Stalks: Identify safe mushroom stalks; some are toxic, so caution is essential
- Nutritional Value: Stalks contain fiber, vitamins, and minerals, contributing to overall health benefits
- Preparation Tips: Trim, clean, and cook stalks properly to enhance texture and flavor
- Common Edible Varieties: Button, shiitake, and oyster mushrooms have edible, tasty stalks
- Potential Risks: Avoid raw or undercooked stalks; some may cause digestive issues

Edible vs. Poisonous Stalks: Identify safe mushroom stalks; some are toxic, so caution is essential
Mushroom stalks, often overlooked, can be a culinary delight or a dangerous gamble. While many edible mushrooms have safe stalks, others harbor toxins concentrated in these very parts. For instance, the Amanita genus, notorious for its deadly species like the Death Cap, contains toxins primarily in the stalk. Conversely, the button mushroom (Agaricus bisporus) boasts a stalk that’s not only edible but also rich in umami flavor, making it a staple in soups and stir-fries. This stark contrast underscores the critical need for precise identification before consumption.
Identifying safe stalks requires more than a casual glance. Key characteristics include color, texture, and the presence of a ring or volva. Edible stalks, like those of the shiitake or oyster mushroom, are typically firm, uniform in color, and free of unusual markings. Poisonous stalks, however, may exhibit a bulbous base, a persistent ring, or a skunky odor. For example, the Amanita muscaria, with its bright red cap and white flecks, has a stalk that often features a distinct volva—a clear warning sign. Always cross-reference with reliable field guides or consult an expert when in doubt.
A practical tip for foragers is the "cut and observe" method. Slice the stalk lengthwise and examine its reaction over time. Edible stalks, like those of the chanterelle, typically remain unchanged or may slightly darken. In contrast, toxic stalks, such as those of the Galerina marginata, may bruise brown or black within minutes—a telltale sign of danger. This simple test, while not foolproof, can help narrow down the safety of a mushroom’s stalk.
Children and pets are particularly vulnerable to accidental poisoning, as they may ingest mushrooms without understanding the risks. Teach children to avoid touching or tasting wild mushrooms, and keep pets on a leash in areas where mushrooms grow. If ingestion occurs, seek immediate medical attention, bringing a sample of the mushroom for identification. Time is critical, as symptoms from toxic stalks can appear within 6–24 hours, ranging from mild gastrointestinal distress to severe organ failure.
In conclusion, while some mushroom stalks are a gourmet’s treasure, others are a forager’s nightmare. Caution, knowledge, and meticulous identification are non-negotiable. When in doubt, discard the stalk entirely—or better yet, the entire mushroom. The thrill of discovery should never outweigh the risk of poisoning. Safe foraging practices ensure that the joy of exploring the fungal kingdom remains a rewarding, not perilous, endeavor.
Sliced Mushrooms: Avoiding Mushy Results in Cooking and Storage
You may want to see also

Nutritional Value: Stalks contain fiber, vitamins, and minerals, contributing to overall health benefits
Mushroom stalks are often discarded, yet they pack a surprising nutritional punch. Rich in dietary fiber, they support digestive health by promoting regular bowel movements and fostering a healthy gut microbiome. A single cup of raw mushroom stalks contains approximately 2 grams of fiber, contributing to the recommended daily intake of 25-30 grams for adults. This makes them a valuable addition to a fiber-rich diet, particularly for those aiming to improve digestive function or manage conditions like constipation.
Beyond fiber, mushroom stalks are a modest source of essential vitamins and minerals. They contain vitamin B, particularly riboflavin (B2) and niacin (B3), which play critical roles in energy metabolism and skin health. Additionally, stalks provide minerals like potassium, important for heart health and muscle function, and selenium, a powerful antioxidant that supports immune function. For instance, a cup of raw mushroom stalks offers around 10% of the daily recommended selenium intake, making them a functional food for boosting antioxidant defenses.
Incorporating mushroom stalks into your diet is simple and versatile. They can be sautéed, roasted, or blended into soups and stews, retaining their nutritional value even when cooked. For a quick snack, slice them thinly, drizzle with olive oil, and roast until crispy for a fiber-rich alternative to chips. Parents can also finely chop stalks and mix them into sauces or casseroles to boost their children’s nutrient intake without altering the dish’s flavor profile.
While mushroom stalks are nutritious, it’s important to prepare them properly. Always clean them thoroughly to remove dirt and potential contaminants. Avoid overcooking, as this can degrade heat-sensitive nutrients like vitamin B. For maximum benefit, pair stalks with vitamin C-rich foods like bell peppers or tomatoes to enhance iron absorption, as mushrooms contain non-heme iron, which is more readily absorbed in the presence of vitamin C.
In comparison to other mushroom parts, stalks often contain higher fiber content but slightly lower concentrations of certain compounds like beta-glucans. However, their nutritional profile remains robust, offering a cost-effective way to diversify your diet. Whether you’re an athlete seeking potassium for muscle recovery, a busy professional needing fiber for sustained energy, or a health-conscious individual aiming to boost antioxidant intake, mushroom stalks are a practical and underutilized resource worth incorporating into your meals.
Mushroom Pills vs. Tapeworms: Can Fungi Cure Parasitic Infections?
You may want to see also

Preparation Tips: Trim, clean, and cook stalks properly to enhance texture and flavor
Mushroom stalks are often discarded, yet they hold untapped potential for enhancing dishes with their earthy flavor and meaty texture. Proper preparation is key to unlocking their culinary value. Start by trimming the tough, fibrous ends, which can be woody and detract from the overall experience. A sharp knife or kitchen shears works best for this task, ensuring a clean cut without damaging the tender parts of the stalk. This simple step transforms the stalk from a potential nuisance into a versatile ingredient.
Cleaning mushroom stalks requires a gentle touch to preserve their integrity. Avoid soaking them in water, as mushrooms absorb moisture like sponges, diluting their flavor and altering their texture. Instead, use a damp cloth or a soft brush to wipe away dirt and debris. For stubborn spots, a quick rinse under cold water followed by patting dry with a paper towel will suffice. This method maintains the stalks’ natural firmness, making them ideal for cooking methods that require structural integrity, such as grilling or roasting.
Cooking mushroom stalks properly can elevate their texture and flavor, turning them into a standout component of any dish. Sautéing in butter or olive oil over medium heat caramelizes their surface, creating a rich, umami-packed exterior while keeping the interior tender. For a smokier profile, try roasting stalks at 400°F (200°C) for 15–20 minutes, tossing them in a mixture of olive oil, garlic, and thyme beforehand. Alternatively, blending stalks into soups or stews adds depth without overpowering other ingredients. Each method highlights a different facet of their flavor, proving their versatility in the kitchen.
A common misconception is that mushroom stalks are inferior to caps, but when prepared thoughtfully, they can be equally delicious. Their firmer texture makes them excellent for stuffing or skewering, while their subtle earthiness complements both bold and delicate flavors. For instance, marinated and grilled stalks pair well with robust ingredients like steak or aged cheese, while finely chopped stalks add a nuanced richness to risottos or omelets. By trimming, cleaning, and cooking stalks with care, you not only reduce food waste but also discover a new dimension in mushroom cuisine.
Enhancing THC Effects: Exploring Mushrooms' Potential Role in Cannabis Synergy
You may want to see also
Explore related products

Common Edible Varieties: Button, shiitake, and oyster mushrooms have edible, tasty stalks
Mushroom stalks are often overlooked, yet they can be a delicious and nutritious addition to your meals, especially when you’re working with varieties like button, shiitake, and oyster mushrooms. These three types are not only widely available but also boast stalks that are both edible and flavorful, making them versatile ingredients in the kitchen. Unlike some mushrooms with tough or bitter stems, these varieties offer stalks that are tender when cooked and complement their caps perfectly.
Button mushrooms, the most common variety found in grocery stores, have stalks that are mild and slightly earthy. They’re ideal for sautéing, grilling, or adding to soups and stir-fries. A practical tip: trim the very bottom of the stalk, as it can sometimes be fibrous, but the rest is fair game. For a simple yet satisfying dish, slice button mushrooms (caps and stalks) and sauté them in butter with garlic and thyme for a side that pairs well with almost anything.
Shiitake mushrooms, prized in Asian cuisine, have stalks that are meatier and more robust than their caps. While some recipes call for discarding the stems due to their toughness when raw, they become tender when cooked properly. A pro tip is to use shiitake stalks to infuse broths or soups with deep umami flavor. Simmer them in a pot of water with kombu seaweed for 30 minutes to create a rich, savory base for ramen or miso soup. Just remember to remove the stalks before serving, as they’ll have done their job.
Oyster mushrooms are a chef’s favorite for their delicate texture and subtle, anise-like flavor. Their stalks are thinner and more tender than those of shiitakes, making them entirely edible without much prep. They’re excellent for stir-fries, pasta dishes, or even as a crispy topping when fried. To highlight their natural taste, try pan-searing oyster mushrooms in olive oil until golden, then finish with a squeeze of lemon and a sprinkle of parsley. Their stalks will add a satisfying bite without overpowering the dish.
Incorporating mushroom stalks into your cooking not only reduces waste but also amplifies the depth of flavor in your dishes. Whether you’re working with button, shiitake, or oyster mushrooms, their stalks are a culinary asset worth exploring. Experiment with different cooking methods to discover how each variety’s stalk can enhance your meals, and you’ll soon find yourself appreciating the whole mushroom, not just the cap.
Can Mushrooms Cause Permanent Damage? Exploring Risks and Realities
You may want to see also

Potential Risks: Avoid raw or undercooked stalks; some may cause digestive issues
Raw or undercooked mushroom stalks can pose significant health risks, particularly for certain varieties. Unlike the caps, which are often consumed raw in salads, stalks contain higher concentrations of chitin—a tough, fibrous material that human digestive systems struggle to break down. This can lead to discomfort, bloating, or even gastrointestinal distress, especially in individuals with sensitive stomachs or pre-existing digestive conditions. For instance, raw shiitake mushroom stalks are known to cause allergic reactions in some people, manifesting as skin rashes or stomach upset. Cooking breaks down chitin, making stalks safer and easier to digest, so always err on the side of caution and apply heat before consumption.
Consider the preparation method as a critical factor in mitigating risks. Boiling, sautéing, or grilling mushroom stalks not only softens their texture but also neutralizes potential toxins present in certain species. For example, the stalks of wild mushrooms like morels or porcini should never be eaten raw due to their naturally occurring hydrazine compounds, which can cause nausea and dizziness. Even common button mushrooms benefit from cooking, as it enhances their flavor and reduces the risk of mild digestive issues. A simple rule of thumb: if you wouldn’t eat the mushroom raw, avoid consuming its stalk uncooked.
Children, the elderly, and individuals with compromised immune systems should exercise extra caution. Their digestive systems may be less equipped to handle the fibrous nature of raw mushroom stalks, increasing the likelihood of adverse reactions. For families, it’s advisable to thoroughly cook all mushroom parts before serving, ensuring they reach an internal temperature of at least 165°F (74°C) to eliminate potential pathogens and toxins. Pairing cooked stalks with digestive enzymes or probiotic-rich foods can further aid in breaking down chitin and preventing discomfort.
Not all mushroom stalks are created equal, and some are entirely safe to eat raw in moderation. Oyster mushroom stalks, for instance, are tender and mild when young, though cooking is still recommended for optimal digestion. However, when in doubt, assume the stalk requires cooking. Always research the specific mushroom variety or consult a mycologist if you’re foraging wild mushrooms. Remember, the goal is to enjoy mushrooms safely, and a few extra minutes of cooking can make all the difference in avoiding unnecessary health risks.
Psychedelic Mushrooms and Dogs: Risks, Myths, and Safety Concerns
You may want to see also
Frequently asked questions
Yes, mushroom stalks are edible for most common varieties like button, cremini, and portobello mushrooms. However, some wild mushrooms have tough or bitter stalks, so always verify the specific type.
Yes, mushroom stalks contain nutrients like fiber, protein, vitamins (e.g., B vitamins), and minerals (e.g., selenium and potassium), similar to the caps.
It’s not necessary to remove the stalks unless they are woody or tough. For most cultivated mushrooms, the stalks can be cooked and eaten along with the caps.
Yes, raw mushroom stalks are safe to eat for common varieties, but cooking them enhances flavor and makes them easier to digest. Always ensure the mushrooms are fresh and properly cleaned.